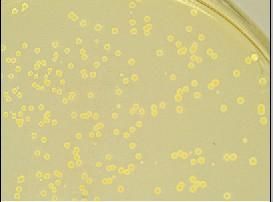
細菌計數

基本資料
細菌計數 counting of bacteria
指測計酵母、細菌等的細胞數。有總菌計數和活菌計數兩種計數法。後者是測計試樣中的活細菌數。二者都是先把試樣稀釋成適於測計的濃度,再用種種方法進行細胞數的測計。一般認為用細胞計數器測計更為精確。有的方法是把細胞用血球容量計進行離心沉澱,從其刻度的容積進行換算;還有一種方法是比濁
細菌計數
細菌計數各種計數
 細菌計數
細菌計數即用血細胞計數器進行計數。取一定體積的樣品細胞懸液置於血細胞計數器的計數室內,用顯微鏡觀察計數。由於計數室的容積是一定的(O.1mm3),因而根據計數器刻度內的細菌數,可計算樣品中的含菌數。本法簡便易行,可立即得出結果。
本法不僅適於細菌計數,也適用於酵母菌及黴菌孢子計數。
2、電子計數器計數法:
電子計數器的工作原理是測定小孔中液體的電阻變化,小孔僅能通過一個細胞,當一個細胞通過這個小孔時,電阻明顯增加,形成一個脈衝,自動記錄在電子記錄裝置上。
該法測定結果較準確,但它只識別顆粒大小,而不能區分是否為細菌。因此,要求菌懸液中不含任何碎片。
3、活細胞計數法
常用的有平板菌落計數法,是根據每個活的細菌能長出一個菌落的原理設計的。取一定容量的菌懸液,作一系列的倍比稀釋,然後將定量的稀釋液進行平板培養,根據培養出的菌落數,可算出培養物中的活菌數。此法靈敏度高,是一種檢測污染活菌數的方法,也是目前國際上許多國家所採用的方法。使用該法應注意:①一般選取菌落數在30~300之間的平板進行計數,過多或過少均不準確;②為了防止菌落蔓延,影響計數,可在培養基中加入O.001%2,3,5一氯化三苯基四氮唑(TTC);③本法限用於形成菌落的微生物。
廣泛套用於水、牛奶、食物、藥品等各種材料的細菌檢驗,是最常用的活菌計數法。
4、比濁法
比濁法是根據菌懸液的透光量間接地測定細菌的數量。細菌懸浮液的濃度在一定範圍內與透光度成反比,與光密度成正比,所以,可用光電比色計測定菌液,用光密度(OD值)表示樣品菌液濃度。
此法簡便快捷,但只能檢測含有大量細菌的懸浮液,得出相對的細菌數目,對顏色太深的樣品,不能用此法測定。
5、測定細胞重量法
此法分為濕重法和乾重法。濕重法系單位體積培養物經離心後將濕菌體進行稱重;乾重法系單位體積培養物經離心後,以清水洗淨放人乾燥器加熱烘乾,使之失去水分然後稱重。
此法適於菌體濃度較高的樣品,是測定絲狀真菌生長量的一種常用方法。
6、測定細胞總氮量或總碳量
氮、碳是細胞的主要成分,含量較穩定,測定氮、碳的含量可以推知細胞的質量。此法適於細胞濃度較高的樣品。
7、顏色改變單位法(colour change unit,簡稱CCU)
這種方法通常用於很小,用一般的比濁法無法計數的微生物,比如支原體等,因為支原體的液體培養物是完全透明的,呈現為清亮透明紅色,因此無法用比濁法來計數,由於支原體固體培養很困難,用cfu法也不容易計數,因此需要用特殊的計數方法,即CCU法。它是以微生物在培養基中的代謝活力為指標,來計數微生物的相對含量的,下面以解脲脲原體為例單介紹其操作:,簡
(1)取12隻無菌試管,每一管裝1.8ml解脲脲原體培養基。
(2)在第一管加入0.2ml待測解脲脲原體菌液,充分混勻,從中吸取0.2ml加入第二管,依次類推,10倍梯度稀釋,一直到最末一管
(3)於37度培養,以培養基顏色改變的最末一管作為待測菌液的CCU,也就是支原體的最大代謝活力,比如第六管出現顏色改變,他的相對濃度就是10的6次方CCU/ml.
一般來說,比濁法和菌落計數法就可以滿足絕大多數細菌的計數,但是對支原體這樣比較特殊的微生物,用CCU法比較合適。

